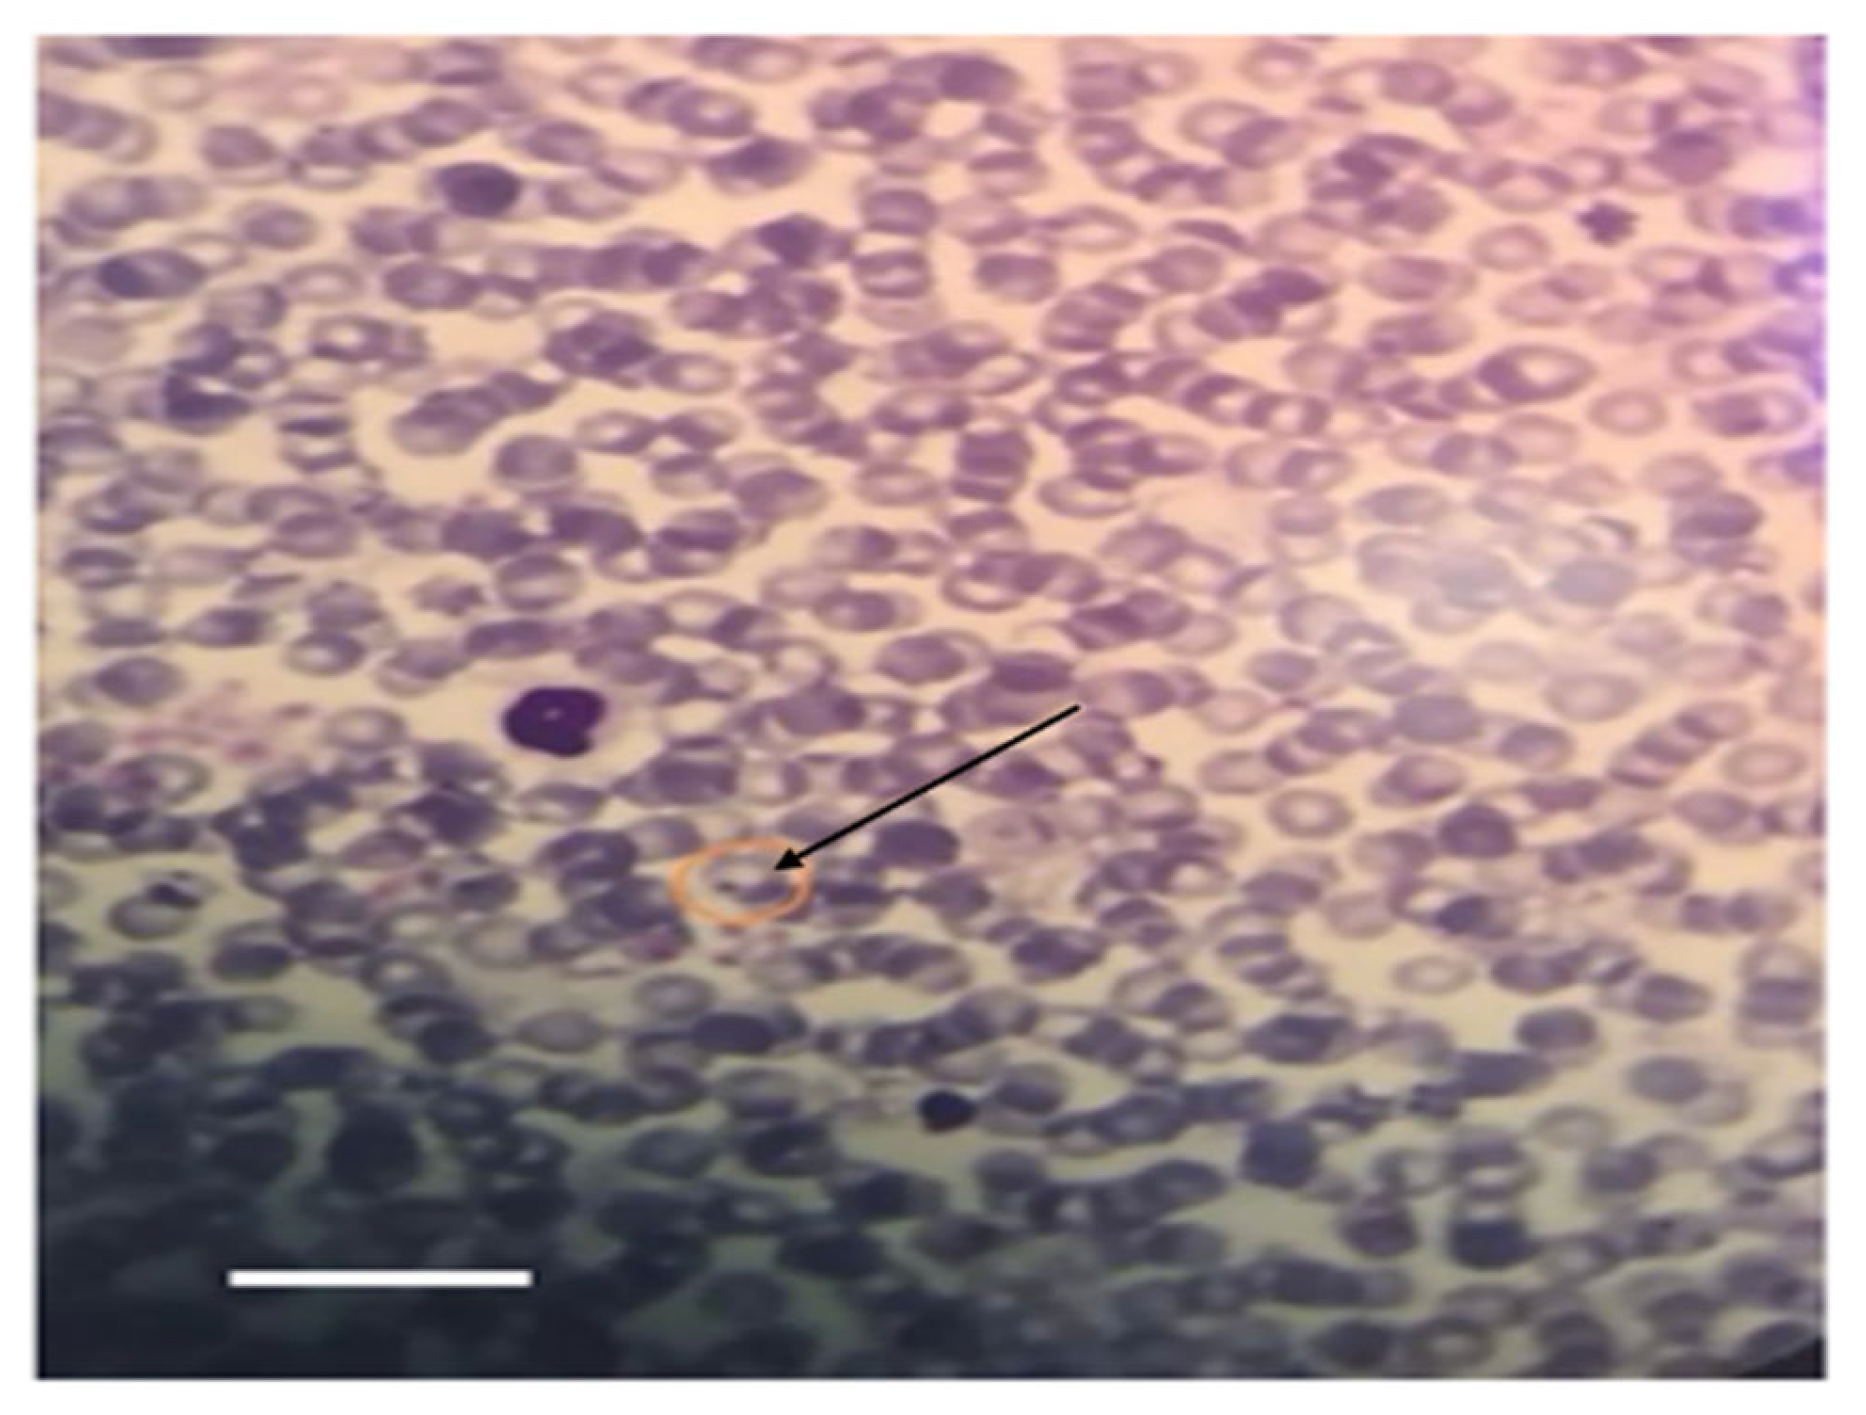

Effects of Tick Infestation on Milk Yield, Blood Biochemistry, Hematology, and the Overall Health of Dairy Cows
Abstract
1. Introduction
2. Materials and Methods
2.1. Study Area
2.2. Animal Selection, Housing, and Study Design
2.3. Tick Collection and Species Identification
2.4. Molecular Identification
2.4.1. DNA Extraction from Ticks
2.4.2. PCR Amplification of the DNA COI Gene
2.4.3. DNA Sequencing and GenBank Accession Numbers and Phylogenetic Analysis
2.5. Blood Samples for Blood Parasite Examination
2.6. Milk Yield Evaluation
Chemical and Mineral Analysis of Cow’s Milk
2.7. Blood Sampling and Biochemical Measurement
2.7.1. Serum Blood Biochemistry Analysis
2.7.2. Hematological Analysis
2.8. Statistical Analysis
3. Results
3.1. Morphological Identification of Ticks
3.2. Molecular Characterization of Tick Infestations
3.3. Phylogenetic Analysis
3.4. Hemoparasite Detection
3.5. The Average Variation in the Production of Milk
3.5.1. Weekly Trends in Milk Yield
3.5.2. Effect of Tick Infection on Milk Components
3.6. Serum Biochemical
3.7. Hematological Results
4. Discussion
5. Conclusions
Supplementary Materials
Author Contributions
Funding
Institutional Review Board Statement
Informed Consent Statement
Data Availability Statement
Acknowledgments
Conflicts of Interest
References
- El-Alfy, E.-S.; Abbas, I.; Saleh, S.; Elseadawy, R.; Fereig, R.M.; Rizk, M.A.; Xuan, X. Tick-borne pathogens in camels: A systematic review and meta-analysis of the prevalence in dromedaries. Ticks Tick-Borne Dis. 2024, 15, 102268. [Google Scholar] [CrossRef]
- Perveen, N.; Muzaffar, S.B.; Al-Deeb, M.A. Ticks and tick-borne diseases of livestock in the Middle East and North Africa: A review. Insects 2021, 12, 83. [Google Scholar] [CrossRef] [PubMed]
- Mishra, G.; Singh, P.; Molla, M.; Yimer, Y.S.; Ewunetie, A.; Tadesse, T.Y.; Ayele, T.M.; Kefale, B. Nutraceuticals: A source of benefaction for neuropathic pain and fibromyalgia. J. Funct. Foods 2022, 97, 105260. [Google Scholar] [CrossRef]
- Bardakci, F.; Al-Subaie, S.H.M.; Badraoui, R.; Adnan, M.; Siddiqui, A.J. Molecular Characterization of Hard Ticks Infesting Camels in the Northern Region of Saudi Arabia Using the Barcoding Gene, Mitochondrial Cytochrome oxidase subunit I. Life 2023, 13, 1535. [Google Scholar] [CrossRef] [PubMed]
- Alanazi, A.D.; Nguyen, V.L.; Alyousif, M.S.; Manoj, R.R.; Alouffi, A.S.; Donato, R.; Sazmand, A.; Mendoza-Roldan, J.A.; Dantas-Torres, F.; Otranto, D. Ticks and associated pathogens in camels (Camelus dromedarius) from Riyadh Province, Saudi Arabia. Parasites Vectors 2020, 13, 1–9. [Google Scholar] [CrossRef]
- Ali, M.; Al-Ahmadi, B.M.; Ibrahim, R.; Alahmadi, S.; Gattan, H.; Shater, A.F.; Elshazly, H. Hard Ticks (Acari: Ixodidae) Infesting Arabian Camels (Camelus dromedarius) in Medina and Qassim, Saudi Arabia. J. Parasitol. 2023, 109, 252–258. [Google Scholar] [CrossRef]
- Kumar, B.; Manjunathachar, H.V.; Ghosh, S. A review on Hyalomma species infestations on human and animals and progress on management strategies. Heliyon 2020, 6, e05675. [Google Scholar] [CrossRef]
- Makwarela, T.G.; Nyangiwe, N.; Masebe, T.M.; Djikeng, A.; Nesengani, L.T.; Smith, R.M.; Mapholi, N.O. Morphological and molecular characterization of tick species infesting cattle in South Africa. Vet. Sci. 2024, 11, 638. [Google Scholar] [CrossRef]
- Alanazi, A.D.; Al-Mohammed, H.I.; Alyousif, M.S.; Said, A.E.; Salim, B.; Abdel-Shafy, S.; Shaapan, R.M. Species diversity and seasonal distribution of hard ticks (Acari: Ixodidae) infesting mammalian hosts in various districts of Riyadh Province, Saudi Arabia. J. Med. Entomol. 2019, 56, 1027–1032. [Google Scholar] [CrossRef]
- Hayati, M.; Hassan, S.; Ahmed, S.; Salih, D. Prevalence of ticks (Acari: Ixodidae) and Theileria annulata infection of cattle in Gezira State, Sudan. Parasite Epidemiol. Control 2020, 10, e00148. [Google Scholar] [CrossRef]
- Senbill, H.; Tanaka, T.; Karawia, D.; Rahman, S.; Zeb, J.; Sparagano, O.; Baruah, A. Morphological identification and molecular characterization of economically important ticks (Acari: Ixodidae) from North and North–Western Egypt. Acta Trop. 2022, 231, 106438. [Google Scholar] [CrossRef]
- Hurtado, O.J.B.; Giraldo-Ríos, C. Economic and health impact of the ticks in production animals. In Ticks and Tick-Borne Pathogens; IntechOpen: London, UK, 2018. [Google Scholar] [CrossRef]
- Al-Musawi, A.M. Genetic Characterization of Hyalomma anatolicum (Ixodoidea: Ixodidae) in Babylon Province, Middle Iraq. SAR J. Pathol. Microbiol. 2023, 4, 73–77. [Google Scholar] [CrossRef]
- Noor, P.S.; Ahmed, M.; Ansari, A.S.; Gadahi, J.A.; Memon, S.B.; Tariq, M.; Laghari, Z.A.; Soomro, F.; Bhutto, B.; Mari, N.-U.-N. Molecular Identification of Hyalomma Ticks and Application of Bacillus thuringiensis Toxins as an Effective Biological Acaricide. J. Parasitol. Res. 2024, 2024, 9952738. [Google Scholar] [CrossRef]
- Nogalska, A.; Momot, M.; Nogalski, Z. The mineral composition of milk from high-yielding dairy cows depending on the month of lactation and udder health. Appl. Sci. 2020, 10, 4803. [Google Scholar] [CrossRef]
- Franzoi, M.; Manuelian, C.L.; Penasa, M.; De Marchi, M. Effects of somatic cell score on milk yield and mid-infrared predicted composition and technological traits of Brown Swiss, Holstein Friesian, and Simmental cattle breeds. J. Dairy Sci. 2020, 103, 791–804. [Google Scholar] [CrossRef] [PubMed]
- Schukken, Y.; Wilson, D.; Welcome, F.; Garrison-Tikofsky, L.; Gonzalez, R. Monitoring udder health and milk quality using somatic cell counts. Vet. Res. 2003, 34, 579–596. [Google Scholar] [PubMed]
- Bilal, M.; Hameed, A.; Ahmad, T. Prevalence of gastrointestinal parasites in buffalo and cow calves in rural areas of Toba Tek Singh, Pakistan. J. Anim. Plant Sci. 2009, 19, 67–70. [Google Scholar]
- Perveen, N.; Bin Muzaffar, S.; Al-Deeb, M.A. Population dynamics of Hyalomma dromedarii on camels in the United Arab Emirates. Insects 2020, 11, 320. [Google Scholar] [CrossRef]
- Garcia, K.; Weakley, M.; Do, T.; Mir, S. Current and future molecular diagnostics of tick-borne diseases in cattle. Vet. Sci. 2022, 9, 241. [Google Scholar] [CrossRef]
- Delpy, L. Les espèces iraniennes du genre Hæmaphysalis Koch, 1844: Identité d’Hæmaphysalis cholodkovskyi Ole-nev, 1928 et d’H. cinnabarina var. cretica Senevet et Caminopetros, 1936. Ann. Parasitol. Hum. Comp. 1938, 16, 1–10. [Google Scholar] [CrossRef]
- Estrada-Peña, A.; Bouattour, A.; Camicas, J.; Walker, A.R. Ticks of Domestic Animals in the Mediterranean Region: A Guide to Identification of Species; University of Zaragoza: Zaragoza, Spain, 2004; 131p. [Google Scholar]
- Diab, F.; Al-Khalifa, M.; Al-Asgah, N.; Hussein, H.; Khalil, G. Ticks (Acari: Argasidae, Ixodidae) infesting livestock in Saudi Arabia. Fauna Arab. 2006, 22, 233. [Google Scholar]
- Al-Shabbani, A.H.; Al-Fatlawi, M.A. Morphological and genotypical identification of Hyalomma anatolicum isolated from cattle in Al-Daghara city, Al-Qadisiyah province, Iraq. Iraqi J. Vet. Sci. 2023, 37, 683–687. [Google Scholar] [CrossRef]
- Binetruy, F.; Dupraz, M.; Buysse, M.; Duron, O. Surface sterilization methods impact measures of internal microbial diversity in ticks. Parasites Vectors 2019, 12, 268. [Google Scholar] [CrossRef] [PubMed]
- Hoffmann, A.; Fingerle, V.; Noll, M. Analysis of tick surface decontamination methods. Microorganisms 2020, 8, 987. [Google Scholar] [CrossRef] [PubMed]
- Folmer, O.; Black, M.; Hoeh, W.; Lutz, R.; Vrijenhoek, R. DNA primers for amplification of mitochondrial cytochrome c oxidase subunit I from diverse metazoan invertebrates. Mol. Mar. Biol. Biotechnol. 1994, 3, 294–299. [Google Scholar]
- Feldman, B.F.; Zinkl, J.G.; Jain, N.C. Schalm’s Veterinary Hematology, 5th ed.; Blackwell Publishing: Ames, IA, USA, 2000. [Google Scholar]
- Soulsby, E.J.L. Helminths, Arthropods and Protozoa of Domesticated Animals, 7th ed.; Baillière Tindall: London, UK, 1982; 809p. [Google Scholar]
- Garaniya, N.; Ramani, H.; Golakiya, B. Comparative Study of Nutrients Profile of Cow Milk at Different Lactation: A Case Study of Gir Cow Milk. J. Dairy Sci. Technol. 2012, 1, 118027. [Google Scholar]
- Monardes, H.G.; Moore, R.K.; Corrigan, B.; Rioux, Y. Preservation and storage mechanisms for raw milk samples for use in milk-recording schemes. J. Food Prot. 1996, 59, 151–154. [Google Scholar] [CrossRef]
- Björn, M.; Nischwitz, V. ICP-MS for the analysis at the nanoscale—A tutorial review. J. Anal. At. Spectrom. 2018, 33, 1432–1468. [Google Scholar]
- Isenberg, B.; Soder, K.; Pereira, A.; Standish, R.; Brito, A. Production, milk fatty acid profile, and nutrient utilization in grazing dairy cows supplemented with ground flaxseed. J. Dairy Sci. 2019, 102, 1294–1311. [Google Scholar] [CrossRef]
- Andrew, B.; Green, M. Use and interpretation of somatic cell count data in dairy cows. Practice 2005, 27, 310–315. [Google Scholar]
- Weiss, D.J.; Wardrop, K. Drug-induced blood cell disorders. In Schalm’s Veterinary Hematology, 6th ed.; Wiley-Blackwell: Hoboken, NJ, USA, 2010; pp. 98–105. [Google Scholar]
- Abbas, A.B.; Yahya, A.; Aloqab, Z.; AlHudhaifi, A.; Alateef, A.A.; Morshed, A.; Qasem, A.; Al-Awlaqi, M.; Alshahari, S.; Mohammed, N. Determination of reference intervals for common liver function tests among healthy adults. Sci. Rep. 2025, 15, 12896. [Google Scholar] [CrossRef]
- Mandic-Havelka, A.; Nilsen, T.; Sunde, K.; Norell, M.; Hansson, L.O.; Larsson, A. Turbidimetric Determination of Fecal Calprotectin Using Two Table Top Chemistry Analyzers: Mindray BS-200E and Cobas® c111. Clin. Lab. 2017, 63, 907–913. [Google Scholar] [CrossRef]
- Leal Yepes, F.A.; Behling-Kelly, E.; Caixeta, L.S.; Tikofsky, L.; Parrish, L.; Heaton, K.N. Evaluation of a point-of-care calcium device in bovine plasma and serum. JDS Commun. 2023, 4, 390–393. [Google Scholar] [CrossRef] [PubMed]
- Dimeski, G.; Badrick, T.; St John, A. Ion selective electrodes (ISEs) and interferences—A review. Clin. Chim. Acta 2010, 411, 309–317. [Google Scholar] [CrossRef] [PubMed]
- Silva, D.T.D.; Alves, M.L.; Spada, J.C.P.; Leonel, J.A.F.; Vioti, G.; Benassi, J.C.; Carregaro, V.M.L.; Alves-Martin, M.F.; Starke-Buzetti, W.A.; Oliveira, T.M.F.S. Feline leishmaniosis: Hematological and biochemical analysis. Rev. Bras. Parasitol. Vet. 2023, 32, e003823. [Google Scholar] [CrossRef] [PubMed]
- Omer, S.A.; Alsuwaid, D.F.; Mohammed, O.B. Molecular characterization of ticks and tick-borne piroplasms from cattle and camel in Hofuf, eastern Saudi Arabia. Saudi J. Biol. Sci. 2021, 28, 2023–2028. [Google Scholar] [CrossRef]
- Al-Khalifa, M.; Hussein, H.; Diab, F.; Khalil, G. Blood parasites of livestock in certain regions in Saudi Arabia. Saudi J. Biol. Sci. 2009, 16, 63–67. [Google Scholar] [CrossRef]
- Al-Deeb, M.A.; Muzaffar, S.B. Prevalence, distribution on host’s body, and chemical control of camel ticks Hyalomma dromedarii in the United Arab Emirates. Vet. World 2020, 13, 114–120. [Google Scholar] [CrossRef]
- Al-Hamadan, N.; Mohammad, J.; Amin, B. Molecular identification and phylogenetic study of ticks (Ixodidae) isolated from small ruminants in Duhok Governorate, Iraq. Basrah J. Vet. Res. 2021, 20, 89–99. [Google Scholar]
- Hosseini-Chegeni, A.; Hosseini, R.; Tavakoli, M.; Telmadarraiy, Z.; Abdigoudarzi, M. The Iranian Hyalomma (Acari: Ixodidae) with a key to the identification of male species. Persian J. Acarol. 2013, 2, 503–529. [Google Scholar]
- Aktaş, M.; Dumanlı, N.; Angın, M. Cattle infestation by Hyalomma ticks and prevalence of Theileria in Hyalomma species in the east of Turkey. Vet. Parasitol. 2004, 119, 1–8. [Google Scholar] [CrossRef]
- Iça, A.; Vatansever, Z.; Yıldırım, A.; Düzlü, Ö.; İnci, A. Detection of Theileria and Babesia species in ticks collected from cattle. Vet. Parasitol. 2007, 148, 156–160. [Google Scholar] [CrossRef]
- Al-Shammery, K.A.; Fetoh, B.; Alshammari, A.M. Differentiation between common tick species using molecular biology techniques in Saudi Arabia. J. World Acad. Sci. Eng. Technol. 2011, 73, 305–307. [Google Scholar]
- Perveen, N.; Muzaffar, S.B.; Al-Deeb, M.A. Prevalence, Distribution, and Molecular Record of Four Hard Ticks from Livestock in the United Arab Emirates. Insects 2021, 12, 1016. [Google Scholar] [CrossRef] [PubMed]
- Wang, J.; Yijun, C.; Yang, J.; Chen, K.; Liu, G.; Luo, J.; Guan, G.; Ren, Q.; Yin, H. Insight into Hyalomma anatolicum biology by comparative genomics analyses. Int. J. Parasitol. 2024, 54, 157–170. [Google Scholar] [CrossRef] [PubMed]
- Fallatah, S.; Ghallab, E.; Khater, E. Phylogenetic diversity and DNA barcoding of the camel tick Hyalomma dromedarii (Acari: Ixodidae) of the Eastern region of Saudi Arabia. Trop. Biomed. 2019, 36, 390–401. [Google Scholar] [PubMed]
- El Kammah, K.M.; Oyoun, L.; El Kady, G.; Shafy, S.A. Investigation of blood parasites in livestock infested with argasid and ixodid ticks in Egypt. J. Egypt. Soc. Parasitol. 2001, 31, 365–371. [Google Scholar]
- Al-Marri, T.M.; Abdally, M.H.; Abdally, H.M.; Al-Jabr, O.A. Incidence and prevalence of hard ticks in ruminants of Al-Ahsa Oasis Region, Kingdom of Saudi Arabia. World Vet. J. 2020, 10, 276–285. [Google Scholar]
- Alanazi, A.D.; Abdulaziz, S.A.; Mohammad, Y.A.; Mohamed, S.A.; Hend, H.A.M.A.; Ahmad, M.A.; Bassma, S.M.E.; Sobhy, A.-S.; Muslimah, N.A.; Khan, A.; et al. Tick burden and molecular detection of tick-borne pathogens in cattle from four regions of Saudi Arabia. Ticks Tick-Borne Dis. 2021, 12, 101652. [Google Scholar] [CrossRef]
- Perveen, N.; Muzaffar, S.B.; Jaradat, A.; Sparagano, O.A.E.; Willingham, A.L. Camel tick species distribution in Saudi Arabia and United Arab Emirates using MaxEnt modelling. Parasitology 2024, 151, 1024–1034. [Google Scholar] [CrossRef]
- Zhao, L.; Lv, J.; Li, F.; Li, K.; He, B.; Zhang, L.; Han, X.; Wang, H.; Johnson, N.; Lin, X. Identification and molecular analysis of ixodid ticks (Acari: Ixodidae) infesting domestic animals and tick-borne pathogens at the Tarim Basin of Southern Xinjiang, China. Korean J. Parasitol. 2020, 58, 37. [Google Scholar] [CrossRef] [PubMed]
- Olcay, H.; Ays, N.O. Distribution and phylogeny of Hyalomma ticks (Acari:Ixodidae) in Turkey. Exp. Appl. Acarol. 2017, 73, 501–519. [Google Scholar]
- Abbasi, F.; Abbasi, I.H.R.; Nissa, T.F.; Bhutto, Z.A.; Arain, M.A.; Soomro, R.N.; Siyal, F.A.; Fazlani, S.A. Epidemiological study of tick infestation in buffalo of various regions of district Khairpur, Pakistan. Vet. World 2017, 10, 688–694. [Google Scholar] [CrossRef] [PubMed][Green Version]
- Ali, S.; Ahmad, A.S.; Ashraf, K.; Khan, J.A.; Rashid, M.I. Insights into the involvement of male Hyalomma anatolicum ticks in transmitting Anaplasma marginale, lumpy skin disease virus and Theileria annulata. Trop. Anim. Health Prod. 2024, 56, 167. [Google Scholar] [CrossRef] [PubMed]
- Al-Fatlawi, M.; Ali, M.; Albayati, H. Morphological and phylogenetic study of Hyalomma anatolicum in Al-Najaf, Iraq. Iraqi J. Vet. Sci. 2019, 32, 261–266. [Google Scholar] [CrossRef]
- Hussain, A.; Hussain, S.; Yu, A.; Varga, C.; De Leo, G.A.; Smith, R.L. Geographical epidemiology of Hyalomma anatolicum and Rhipicephalus microplus in Pakistan: A systematic review. PLoS ONE 2024, 19, e030944239178282. [Google Scholar] [CrossRef]
- Dantas-Torres, F.; Chomel, B.B.; Otranto, D. Ticks and tick-borne diseases: A One Health perspective. Trends Parasitol. 2012, 28, 437–446. [Google Scholar] [CrossRef]
- Abdel-Shafy, S.; Allam, N.A.; Mediannikov, O.; Parola, P.; Raoult, D. Molecular detection of spotted fever group rickettsiae associated with ixodid ticks in Egypt. Vector-Borne Zoonotic Dis. 2012, 12, 346–359. [Google Scholar] [CrossRef]
- Zeb, J.; Song, B.; Khan, M.A.; Senbill, H.; Aziz, M.U.; Hussain, S.; Díaz Sánchez, A.A.; Cabezas-Cruz, A.; Alzahrani, A.; Alshehri, M.; et al. Genetic diversity of tick-borne zoonotic pathogens in ixodid ticks collected from small ruminants in Northern Pakistan. Infect. Genet. Evol. 2024, 124, 105663. [Google Scholar] [CrossRef]
- Dabaja, M.F.; Tempesta, M.; Bayan, A.; Vesco, G.; Greco, G.; Torina, A.; Blanda, V.; La Russa, F.; Scimeca, S.; Lelli, R. Diversity and distribution of ticks from domestic ruminants in Lebanon. Vet. Ital. 2017, 53, 147–155. [Google Scholar]
- Al-Hamadan, H.Z.; Al-Khafaji, A.M.; Mero, W.M.; Al-Attar, M.A.A. Molecular identification of hard ticks (Acari: Ixodidae) infesting cattle in Iraq using mitochondrial 12S and 16S rRNA genes. Vet. World 2021, 14, 1295–1301. [Google Scholar]
- Latif, A.; Bakheit, M.; Mohamed, A.E.; Zweygarth, E. High infection rates of the tick Hyalomma anatolicum anatolicum with Trypanosoma theileri. Onderstepoort J. Vet. Res. 2004, 71, 251–256. [Google Scholar] [CrossRef] [PubMed]
- Hassan, M.I.; Gabr, H.S.; Abdel-Shafy, S.; Hammad, K.M.; Mokhtar, M.M. Prevalence of tick-vectors of Theileria annulata infesting the one-humped camels in Giza, Egypt. J. Egypt. Soc. Parasitol. 2017, 47, 425–432. [Google Scholar] [CrossRef]
- EI-Metenawy, T.M. Prevalence of Theileria spp. in cattle in Qassim region, Saudi Arabia—Microscopy survey. Vet. Parasitol. 1999, 99, 305–312. [Google Scholar]
- De Castro, J.J. Sustainable tick and tick-borne disease control in livestock improvement in developing countries. Vet. Parasitol. 1997, 71, 77–97. [Google Scholar] [CrossRef]
- Bondan, C.; Folchini, J.A.; Noro, M.; Quadros, D.L.; Machado, K.M.; González, F.H.D. Milk composition of Holstein cows: A retrospective study. Ciência Rural. 2018, 48, e20180123. [Google Scholar] [CrossRef]
- Norval, R.A.I.; Sutherst, R.W.; Gibson, J.D.; Kerr, J.D.; Thorne, L.M.; Ellenhauge, A. The effects of the brown ear-tick, Rhipicephalus appendiculatus, on milk production in dairy cattle. Med. Vet. Entomol. 1997, 11, 155–158. [Google Scholar] [CrossRef]
- Satti, R.A.; Awadelkareem, E.A.; Suganuma, K.; Salim, B.; Inoue, N.; Xuan, X.; Rehan, S.; Mossaad, E. Cattle anaplasmosis and babesiosis: Major tick-borne diseases affecting the cattle industry in Khartoum State, Sudan. Vet. Parasitol. Reg. Stud. Rep. 2021, 26, 100–220. [Google Scholar] [CrossRef]
- Azambuja, R.C.; Rodrigues, P.F.; Menezes, L.M.; Costa, R.F.; Teixeira, B.B.; Mendonça, F.S.; Suñé, R.W.; Silveira, I.D.; Cardoso, F.F. Milk Production and Constituents of Beef Cows with Different Breed Compositions. Res.Sq. 2020. Preprint Version 1. [Google Scholar] [CrossRef]
- Addo, S.O.; Bentil, R.E.; Mosore, M.-T.; Behene, E.; Adinkrah, J.; Tagoe, J.; Yeboah, C.; Baako, B.O.A.; Atibila, D.; Kwarteng, S.A. Risk factors affecting the feeding site predilection of ticks on cattle in Ghana. Exp. Appl. Acarol. 2024, 92, 835–850. [Google Scholar] [CrossRef]
- Paucar-Quishpe, V.; Pérez-Otáñez, X.; Rodríguez-Hidalgo, R.; Pérez-Escalante, C.; Cepeda-Bastidas, D.; Grijalva, J.; Enríquez, S.; Arciniegas-Ortega, S.; Vanwambeke, S.O.; Ron-Garrido, L. Farmers’ adoption, knowledge, and perceptions of tick control measures on dairy farms in subtropical areas of continental Ecuador. Transbound. Emerg. Dis. 2024, 2024, 5023240. [Google Scholar] [CrossRef] [PubMed]
- Abbas, H.; Rizwan, H.M.; Younus, M.; Farid, M.U.; Naeem, M.A.; Ali Taseer, M.S.; Asghar, M.; Sargison, N.; Opara, M. Parasite control strategies: Trace elements and minerals. In Parasitism and Parasitic Control in Animals; CIBA: Basle, Switzerland, 2023; pp. 201–216. [Google Scholar]
- Radostits, O.M.; Gay, C.; Hinchcliff, K.W.; Constable, P.D. A textbook of the diseases of cattle, horses, sheep, pigs and goats. Vet. Med. 2007, 10, 2045–2050. [Google Scholar]
- Noha, N.Y.; Fadwa, A.E.; Ibrahim, A.S.; Mahmoud, F.A. Impact of tick infestation and blood parasites on milk minerals, production, and reproductive performance in dairy cattle. Egypt. Vet. Med. Soc. Parasitol. J. 2024, 18, 49–59. [Google Scholar]
- Ibrahim, N.; Kirmani, M.A. Milk fever in dairy cows: A systematic review. Res. J. Biol. 2021, 9, 1–12. [Google Scholar]
- Karim, S.; Budachetri, K.; Mukherjee, N.; Williams, J.; Kausar, A.; Hassan, M.J.; Adamson, S.; Dowd, S.E.; Apanskevich, D.; Arijo, A. A study of ticks and tick-borne livestock pathogens in Pakistan. PLoS Neglected Trop. Dis. 2017, 11, e0005681. [Google Scholar] [CrossRef]
- Jonsson, N.; Davis, R.; De Witt, M. An estimate of the economic effects of cattle tick (Boophilus microplus) infestation on Queensland dairy farms. Aust. Vet. J. 2001, 79, 826–831. [Google Scholar] [CrossRef]
- Dank, M.; Holzhauer, M.; Veldhuis, A.; Frankena, K. Association between Dictyocaulus viviparus status and milk production parameters in Dutch dairy herds. J. Dairy Sci. 2015, 98, 7741–7747. [Google Scholar] [CrossRef]
- El-Tarabany, M.S.; Atta, M.A.; El-Tarabany, A.A. Impact of heat stress on health and performance of dairy animals: A review Impact parasitic infection on milk yield, composition, and oxidative stress biomarkers in Holstein dairy cows. Livest. Sci. 2018, 216, 200–204. [Google Scholar]
- Tsioulpas, A.; Grandison, A.; Lewis, M. Changes in physical properties of bovine milk from the colostrum period to early lactation. J. Dairy Sci. 2007, 90, 5012–5017. [Google Scholar] [CrossRef]
- Kumar, P.; Kumar, P.; Roy, R.K.; Kumari, R.R.; Kumar, A.; Sarma, K.; Sharma, P.; Kumar, M. Mixed infection of tick-borne haemo-parasites in water buffalo and associated pathological responses and treatment. Indian. J. Anim. Res. 2022, 56, 978–986. [Google Scholar] [CrossRef]
- Sumon, S.M.R.; Parvin, M.S.; Ehsan, M.A.; Islam, M.T. Dynamics of somatic cell count and intramammary infection in lactating dairy cows. J. Adv. Vet. Anim. Res. 2020, 7, 314. [Google Scholar] [CrossRef]
- Saleem, M.; Akhtar, T.; Ahmad, M.; Khan, M.F.; Shakoori, A.R. Hematobiochemical alterations in crossbred cattle naturally infected with babesiosis. Pak. J. Zool. 2020, 52, 1407–1412. [Google Scholar]
- Goswami, R.; Arora, N.; Mrigesh, M.; Arya, D. Impact of tick infestation on haematological and biochemical profiles in cattle: A comparative study. Int. J. Adv. Biochem. Res. 2024, 8, 579–583. [Google Scholar] [CrossRef]
- Kim, Y.; Ku, J.-Y.; Jung, Y.; Lim, Y.-H.; Ji, M.-J.; Park, Y.-J.; Cho, H.-C.; Choi, K.-S.; Park, J. Evaluation of haematological parameters in haemolytic anaemia caused by tick-borne pathogens in grazing cattle. Vet. Med. Sci. 2024, 10, e1434. [Google Scholar] [CrossRef]
- Nazifi, S.; Razavi, S.M.; Kaviani, F.; Rakhshandehroo, E. Acute phase response in cattle infected with Anaplasma marginale. Vet. Microbiol. 2012, 155, 267–271. [Google Scholar] [CrossRef]

| Parameter | Tick-Infested Cows (Mean ± SE) | Healthy Cows (Mean ± SE) | % Difference | p-Value |
|---|---|---|---|---|
| Daily Milk Yield—Morning (L) | 6.62 ± 0.37 | 11.23 ± 0.005 | ↓ 41.0% | <0.0001 |
| Daily Milk Yield—Afternoon (L) | 6.13 ± 0.31 | 11.32 ± 0.006 | ↓ 45.9% | <0.0001 |
| Calcium (mg/L) | 820.85 ± 8.75 | 1178.45 ± 10.30 | ↓ 69.7% | <0.0001 |
| Potassium (mg/L) | 939.25 ± 5.90 | 1587.36 ± 3.35 | ↓59.2% | <0.0001 |
| Protein (%) | 1.34 ± 0.02 | 3.81 ± 0.06 | ↓ 64.8% | <0.0001 |
| Fat (%) | 1.15 ± 0.04 | 3.48 ± 0.09 | ↓ 66.9% | <0.0001 |
| SCC (×103/mL) | 580 ± 120 | 310 ± 95 | ↑ 87.1% | <0.01 |
| Parameter | Tick-Infested Cows (Mean ± SE) | Healthy Cows (Mean ± SE) | % Difference | p-Value |
|---|---|---|---|---|
| AST (IU/L) | 140.50 ± 1.20 | 41.50 ± 1.30 | ↑ 238.6% | <0.0001 |
| Creatinine (mg/dL) | 8.00 ± 0.20 | 0.90 ± 0.05 | ↑ 788.9% | <0.0001 |
| Urea (mg/dL) | 32.20 ± 1.00 | 14.00 ± 0.90 | ↑ 130.0% | <0.0001 |
| GGT (IU/L) | 33.50 ± 1.10 | 13.10 ± 0.80 | ↑ 155.7% | <0.0001 |
| Calcium (mg/dL) | 7.50 ± 0.90 | 12.40 ± 0.60 | ↓ 39.5% | <0.0001 |
| Potassium (mmol/L) | 2.44 ± 0.17 | 4.45 ± 0.63 | ↓ 45.2% | <0.0001 |
| Parameter | Tick-Infested Cows (Mean ± SE) | Healthy Cows (Mean ± SE) | % Difference | p-Value |
|---|---|---|---|---|
| WBC (×103/µL) | 25.50 ± 0.90 | 17.60 ± 0.70 | ↑ 44.9% | <0.0001 |
| RBC (×106/µL) | 19.10 ± 0.60 | 8.50 ± 0.50 | ↑ 124.7% | <0.0001 |
| HGB (g/dL) | 3.00 ± 0.20 | 6.40 ± 0.30 | ↓ 53.1% | <0.0001 |
| HCT (%) | 45.70 ± 0.50 | 47.20 ± 0.40 | ↓ 3.2% | <0.0001 |
Disclaimer/Publisher’s Note: The statements, opinions and data contained in all publications are solely those of the individual author(s) and contributor(s) and not of MDPI and/or the editor(s). MDPI and/or the editor(s) disclaim responsibility for any injury to people or property resulting from any ideas, methods, instructions or products referred to in the content. |
© 2025 by the authors. Licensee MDPI, Basel, Switzerland. This article is an open access article distributed under the terms and conditions of the Creative Commons Attribution (CC BY) license (https://creativecommons.org/licenses/by/4.0/).
Share and Cite
Al-Shammari, M.; Alanazi, I.O.; Alzahrani, M.; Alotaibi, S.; Alkahtani, N.; Alaqil, A.; Al-Olayan, E. Effects of Tick Infestation on Milk Yield, Blood Biochemistry, Hematology, and the Overall Health of Dairy Cows. Pathogens 2025, 14, 883. https://doi.org/10.3390/pathogens14090883
Al-Shammari M, Alanazi IO, Alzahrani M, Alotaibi S, Alkahtani N, Alaqil A, Al-Olayan E. Effects of Tick Infestation on Milk Yield, Blood Biochemistry, Hematology, and the Overall Health of Dairy Cows. Pathogens. 2025; 14(9):883. https://doi.org/10.3390/pathogens14090883
Chicago/Turabian StyleAl-Shammari, Mona, Ibrahim O. Alanazi, Mohammad Alzahrani, Samiah Alotaibi, Nora Alkahtani, Almaha Alaqil, and Ebtesam Al-Olayan. 2025. "Effects of Tick Infestation on Milk Yield, Blood Biochemistry, Hematology, and the Overall Health of Dairy Cows" Pathogens 14, no. 9: 883. https://doi.org/10.3390/pathogens14090883
APA StyleAl-Shammari, M., Alanazi, I. O., Alzahrani, M., Alotaibi, S., Alkahtani, N., Alaqil, A., & Al-Olayan, E. (2025). Effects of Tick Infestation on Milk Yield, Blood Biochemistry, Hematology, and the Overall Health of Dairy Cows. Pathogens, 14(9), 883. https://doi.org/10.3390/pathogens14090883

